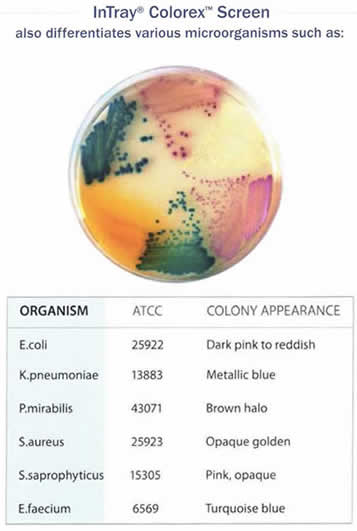

El Kit de Diagnostico Microbiologico para el Consultorio Intray Colorex Screen ha sido diseñado para un uso sencillo y rápido y NO requiere de equipos de laboratorio o envió de muestras a terceros. Su uso es para el Consultorio Veterinario. El Kit de Diagnostico Microbiologico Urinario Intray Colorex Screen es para un Aislamiento y diferenciación rápida de patógenos en el tracto urinario.
Derechos Reservados © 2016 Biotech Col